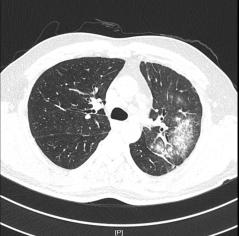

原创 廖庆峰 医学界呼吸频道

病例简介
▎一般情况
患者,男,52岁。
▎主诉
咳嗽、咳血痰1月余,加重4天。
▎现病史
患者1月余无明显诱因下出现咳出鲜红色及暗红色血痰,早晨时明显。
当地附属医院住院拟“肺炎”治疗。
2020年5月14日行胸部CT:
1.左肺上叶炎症;
2.右肺上叶尖段慢性炎症;
3.两肺上叶、左肺下叶局限性肺气肿;
给以哌拉西林、莫西沙星、多西环素抗感染治疗,治疗后仍有咳嗽及血丝痰。
2020年5月24日复查胸部CT:
左肺上叶炎症,较前进展;
右肺上叶间质性病变,考虑间质性肺水肿;
右肺上叶尖段慢性炎症。
遂自行出院,出院后反复有咳嗽及血丝痰。
入院4天前患者自觉咳嗽较前频繁激烈,痰液较前黏稠,鲜红色血痰较前增多,伴有夜间盗汗。
遂至我院门诊就诊,门诊拟“咯血查因”收入我科。
▎既往史
自诉有“心房颤动”16年,长期未规范治疗,2019年因“心房颤动”当地医院行“射频消融”治疗。
▎入院专科查体
SpO2:98%(吸空气下),左侧肺闻及湿性啰音,无哮鸣音及胸膜摩擦音,未闻及Velcro啰音。语音传导无异常,律齐,各瓣膜听诊区未闻及干湿性啰音,双下肢无浮肿。
▎入院诊断
咯血查因,肺结核?肺泡出血?
入院后予以行抗感染、止血,并进一步完善相关检查,鉴别咯血原因。
▎实验室检查
嗜酸性粒细胞比率:11.3%;嗜酸性粒细胞数:0.60×109/L;肝功八项谷丙转氨酶40.3 U/L;C反应蛋白1.81 mg/dL。
▎感染指标
痰细菌涂片:一般细菌涂片检查:G+球菌及G-杆菌 ;
G试验:178.66 pg/mL;
九项呼吸道感染、结核菌涂片、TB-DNA、Xpert、结核感染T细胞检测、结核菌涂片检查、GM试验、PCT未见异常。
▎风湿免疫相关指标
抗环瓜氨酸肽抗体、抗核抗体普十一项、ANCA阴性、抗心磷脂抗体两项、抗核抗体定量(ANA)、ENA多肽未见明显异常。
▎其他指标
肌钙蛋白T、D-二聚体、血传播、PRO-BNP正常。肿瘤标志物正常。
▎肺部增强CT(图片如下)

2.右上肺尖段少许慢性炎症;
3.纵隔多发肿大淋巴结,拟反应性增生,建议随诊;
4.拟左上肺多发体-肺动脉分流形成;
5.支气管动脉重建示左侧支气管动脉稍增粗。
▎心脏彩超
心内结构及血流未见明显异常。左室收缩功能未见异常。
▎思路
患者外院以及入院后行抗感染治疗无效,患者仍反复咯血?
反复阅读肺部CT并与影像科同事联系,患者肺部CT提示间质水肿、左肺上静脉显示不清,结合患者存在射频消融史,需要考虑肺静脉狭窄引起的咯血。
▎下一步行右心导管、左心导管、肺动脉造影术
送入猪尾巴导管至双肺动脉造影示,左肺动脉造影见左上肺外周血管未显影,未见左上肺静脉回流,左下肺动脉显影良好,左下肺静脉回流尚好。
右肺动脉造影见右上肺动脉显影好,右上肺静脉回流尚可,进入左心房入处狭窄,约30%,右下肺动脉显影好,右下肺静脉回流尚可。超选LA1支造影显示左上肺静脉回流至左房入口处明显狭窄,约90%,左肺静脉回流处血管团造影剂渗出。
▎到此明确诊断
1.左上肺静脉闭塞;
2.房颤射频消融术后。
▎治疗:右心导管检查+肺动脉造影+肺静脉血管腔内成形。术后未再咯血。
讨论
肺静脉狭窄( pulmonary venous stenosis,PVS)是指由于各种因素造成肺静脉管腔狭窄,导致肺静脉血液回流受阻,可表现反复的咯血,部分患者以咯血为首发症状到呼吸科就诊。
随着近年来射频消融术在房颤治疗中的广泛应用,PVS已是其严重的并发症之一,狭窄程度可从轻度至完全静脉闭塞。
射频消融所致 PVS的机制之一
射频消融的热损伤导致肺静脉血管壁瘢痕形成及肺静脉收缩,病理表现为过度反应的胶原组织代替坏死的肌肉组织,以及炎症反应参与,最终出现管壁结构的重塑、内膜增生等,并引起肺静脉压增高、肺静脉血回心受阻,从而出现肺淤血,最终导致肺高压、 右心室压力负荷增加,引发咯血等临床症状。
PVS在术后第1周进展最快;其次是术后3 个月内;术后6个月出现的迟发性PVS较少见。
诊断PVS的方法有CT肺血管造影、MRA、心脏彩超及肺通气/灌注扫描等无创性检查,金标准是肺静脉造影。肺静脉造影属于有创性检查,不作为首选。
对于大多数基层医院,首选建议肺静脉增强CT检查及血管三维重建、心脏彩超。
其中肺静脉增强CT检查及血管三维重建诊断PSV效果明显,该例患者我院首先完善了肺部动脉增强CT,影像科医生在报告中未报左肺静脉异常,我们反复阅读片子发现左肺静脉异常,从而进一步行右心导管、左心导管、肺动脉造影术,以此明确诊断;而使用心脏彩超诊断PVS中需警惕因操作者主观因素导致的诊断遗漏,注意加强与辅助科室之间的提醒。
本例患者我院心脏彩超也未能报告肺静脉异常。患者辗转多家医院未见查清咯血原因,缺少对患者既往行射频消融术引起的肺静脉狭窄的警惕,从而未能选择适当的辅助检查,从而造成漏诊、误诊。
其实真凶就隐藏在既往病史中。
总结
咯血是呼吸内科常见一类疾病症状,常见原因依次为:肺结核、支气管扩张、肺癌、感染。
但呼吸科医生可能对咯血为首发症状的肺静脉狭窄尚缺乏足够的诊治经验,容易造成误诊、漏诊。
通过此病例,加强对射频消融术后患者咯血原因的警惕,及时完善CT血管增强以及心脏彩超明确诊断。
参考文献:
[1] Packer DL,Keelan P,Munger TM,et al.Clinical presentation,investigation,and management of pulmonary vein stenosis complicating ablation for atrial fibrillation.Circulation,2005,111:546-554.
[2] 吴钢,黄从新,江洪.射频消融致肺静脉狭窄的病理特征.中华心血管病杂志,2004,32:539-540.
[3]孔令秋,唐红,冯沅,等.心房颤动射频消融术后肺静脉狭窄超声表现l例.中华超声影像学杂志,2014,23:661.
[4]罗学胜,张红,刘建民,等.心房颤动患者射频消融术后肺静脉狭窄误诊分析.临床误诊误治,2012,25:62-64.
[5]Rostamian A,Narayan SM,Thomson L,et a1.The incidence,diagnosis,and management of pulmonary vein stenosis as a complication of atrial fibrillation ablation.J Interv Card Electrophysiol.2014,4063-74.
[6]Barrett CD,Di Biase L,Natale A.How to identify and treat patient with pulmonary vein stenosis post atrial fibrillation ablation.Curt Opin Cardiol,2009,24:42—49.
[7]蔡柏蔷,李龙芸.协和呼吸病学[M].2版.北京:中国协和医 科大学出版社,2011:196.
[8]张明,周唐婷,吴学玲.中华结核和呼吸杂志2015,9:688-701.
本文首发:医学界呼吸频道
本文作者:廖庆峰
